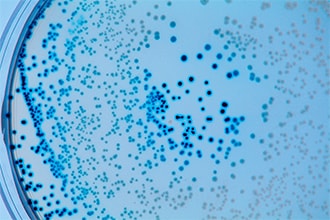

Food Contamination
Food contamination is caused by harmful substances contained in the food itself, microorganisms and bacteria caused by poor hygiene control, and foreign substances introduced in the manufacturing process. There is a risk of health hazards if you consume foods that contain more than the safety standards. To protect food safety, various analyses are being conducted on the causes of food contamination.

Per- and polyfluoroalkyl substances (PFAS) were widely applied chemicals: they were used in packaging, as water and oil repellants, as well as fire-fighting coatings. Leaching from packaging materials and contaminating water sources, these persistent chemicals find their way into our food chain, raising concerns about long-term health effects. With growing evidence linking PFAS exposure to adverse health effects, testing for PFAS in our food is crucial in keeping us safe and healthy.
Microbial contamination of food can cause serious food poisoning. Quality control of microbial contamination is important.

Environmentally derived carcinogens may contaminate food. Monitoring technology for these materials is also important.

Food can undergo various changes due to heating, spoilage, and the effects of enzymes, sometimes producing substances that can harm people.

There are cases where foreign substances get into food in food production lines, during transportation, and at retail stores. Identifying the foreign material is essential to determining the route of contamination.



